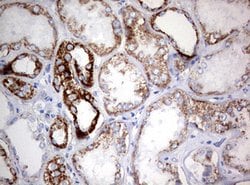
NDUFS2 Mouse anti-Human, Clone: OTI1D5, lyophilized, TrueMAB 100 &mu;g;
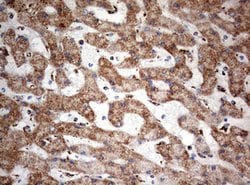
NDUFS2 Mouse anti-Human, Clone: OTI1D5, lyophilized, TrueMAB 100 &mu;g;

Learn More
NDUFS2 Mouse anti-Human, Clone: OTI1D5, lyophilized, TrueMAB™
Mouse Monoclonal Antibody
Brand: Origene Technologies CF802340

Description
Reconstitute with PBS (pH 7.3) and recommend to perform another round of desalting process using Product No. 7KMWCO
NDUFS2 is a core subunit of the mitochondrial membrane respiratory chain NADH dehydrogenase (complex I). Mammalian mitochondrial complex I is composed of at least 43 different subunits, 7 of which are encoded by the mitochondrial genome, and the rest are the products of nuclear genes. The iron-sulfur protein fraction of complex I is made up of 7 subunits, including this gene product. Complex I catalyzes the NADH oxidation with concomitant ubiquinone reduction and proton ejection out of the mitochondria.Specifications
| NDUFS2 | |
| Monoclonal | |
| Unconjugated | |
| NDUFS2 | |
| CI-49 | |
| Mouse | |
| Affinity Chromatography | |
| RUO | |
| 4720 | |
| -20° C, Avoid Freeze/Thaw Cycles | |
| Lyophilized |
| Immunohistochemistry (Paraffin), Western Blot | |
| OTI1D5 | |
| PBS with 8% trehalose and no preservative; pH 7.3 | |
| O75306 | |
| NDUFS2 | |
| Human recombit protein fragment corresponding to amino acids 205-463 of human NDUFS2 produced in E.coli. | |
| 100 μg | |
| Primary | |
| Human | |
| Antibody | |
| IgG1 |
The Fisher Scientific Encompass Program offers items which are not part of our distribution portfolio. These products typically do not have pictures or detailed descriptions. However, we are committed to improving your shopping experience. Please use the form below to provide feedback related to the content on this product.